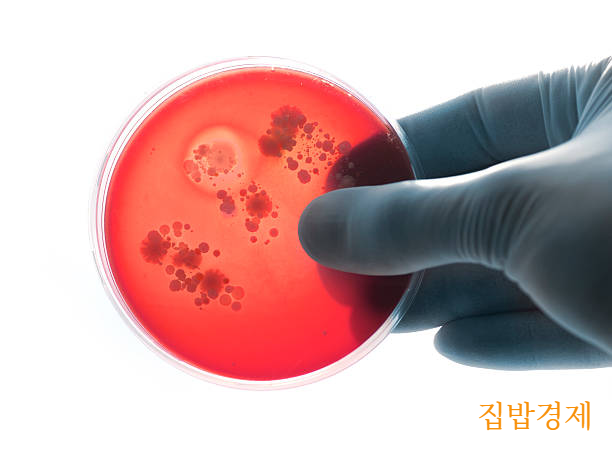

반응형
감기인 줄 알았는데 알고 보니 인지장애, 언어장애, 발달장애 후유증을 남길 수 있는 질환이 바로 뇌수막염인데요

특히 세균성인 경우 초기에 치료하지 않으면 심각한 후유증을 남길 수 있고 심하면 사망에 이를 수 있다고해요
이번 시간에는 이 질환에 대하여 알아보고 치료법에 대하여 알아볼게요
정의

뇌수막염이란 뇌와 척수를 포함한 중추신경을 감싸고 있는 뇌척수막에 염증이 생기는 질환을 말한는데요
중추신경
뇌와 척수로 구성되며 이것은 뇌척수막이라는 세겹의 막에 싸여 보호
특정 형태의 경우에는 병의 경과가 심각하지 않고 특별한 치료 없이도 스스로 회복 될 수도 있지만 심각한 신경학적 손상을 초래하여 환자에 장애를 남기고 심하면 사망에 이를 수 있어 매우 심각한 질환이라고 할 수 있어요
원인
감염성 (바이러스, 세균)과
비감염성으로 구분

감염성
- 바이러스, 세균, 진균, 기생충에 의해 대부분 발생
- 감염원들에 의해 혈액 속으로 들어가 뇌척수에 침입
바이러스에 의한 감염
- 코나 입으로 침입하여 중추 신경계까지 침투
- 대부분 수일 내에 자가 치유
세균에 의한 감염인 경우
- 드물지만 치명적
- 흔한 감기 증상으로 시작으로 인해 진단이 늦어짐
- 위험한 상태에 이를 수 있어 치명적
- 세균성 뇌수막염인지 감별해 내는 것이 중요
발생시키는 균
뇌막알균, 폐렴사슬알균, 황색포도알균, 리스테리아균, B형 인플루엔자균, 결핵균
비감염성
- 암, 전신홍반루프스 특정 약물에 대한 염증 반응
증상
두통이 가장 대표적이며
경부 경직이 흔함

전형적인 증상
- 두통, 경부 경직, 발열
경부 경직
목을 구부려 앞으로 머리를 굽힐 수 없는 상태
이외에 증상
- 눈부심, 고성공포증, 구토, 목과 다리의 통증 등
- 소아의 경우: 섬망, 경련 등이 나타남
진단
뇌척수액 검사

뇌척수액
지주막 속에 들어있는 액체로서 뇌막과 뇌척수 사이를 채우고 있기때문에 뇌척수액을 뽑아 검사
뇌수막염을 진단하데 필요한 다양한 정보
요추 천자를 시행
환자가 옆으로 웅크리고 누운 자세에서 등을 통해 가늘고 긴 바늘을 찔러 채취
치료

세균성 감염
진단결과 나오기 전까지 경험적 항생제 투여
원인균이 나오면 원인균에 적합한 항생제 투여
보조치료로 스테로이드제를 사용
사망률을 줄이고 심각한 청력 손실과 신경학적 후유증이 줄이기 위해 사용
바이러스성 감염
특별한 치료약은 없으며 경증인 경우 관찰 치료로 호전
경증보다 심한 경우는 입원하여 대증적 치료
헤르페스 바이러스에 의한 것이 확실한 경우 아시클로버를 투여
진균성인 경우
건강한 사람에게는 극히 드물게 발생
면역결핍상태 (에이즈)이거나 면역억제상태인 환자에게 발병
오랜 기간동안 항진균제로 치료가 필요
예방
백신으로 예방하기

백신
현재의 모든 백신은 일부 세균성 뇌수막염을 대상
헤모필루스 인플루엔자b 백신 (Hib 백신)
선별 예방접종
2, 4, 6 개월에 실시 / 12~15개월에 추가 접종
폐렴구균 다당류 백신
모든 65세 이상의 사람들에게 접종 권고
뇌수막염에 대하여 알아보았는데요
어떻게 도움과 이해가 되셨는지요?
특히 뇌수막염은 뇌에 침범하였을 경우 매우 예후가 좋지 않기때문에 각별한 주의가 필요한데요
증상이 감기와 비슷해 진단이 늦어지지 않도록 하는 것이 무엇보다 중요해요
우리 모두 건강하고 행복하게 사는 그날까지 더 알차고 건강한 정보로 찾아뵐게요
읽어주셔서 감사합니다
반응형
'중년건강정보' 카테고리의 다른 글
| 오래 걷기 힘들고 다리가 저리다면 척추관 협착증 증상 및 치료 수술 추간공 확장술 (24) | 2023.03.02 |
|---|---|
| 초기증상이 없어 위험한 난소암 원인과 증상 및 치료와 예방법 (17) | 2023.02.27 |
| 우리 몸과 마음을 위협하는 섭식 장애 증상 및 원인과 치료 (18) | 2023.02.23 |
| 성장판이 조기 폐쇄될 수 있는 성조숙증 증상 및 원인과 치료 / 남자아이와 여자아이 차이 (20) | 2023.02.21 |
| 아기의 건강한 탄생을 위한 임신중독증 증상 및 원인 그리고 예방법 (19) | 2023.02.20 |